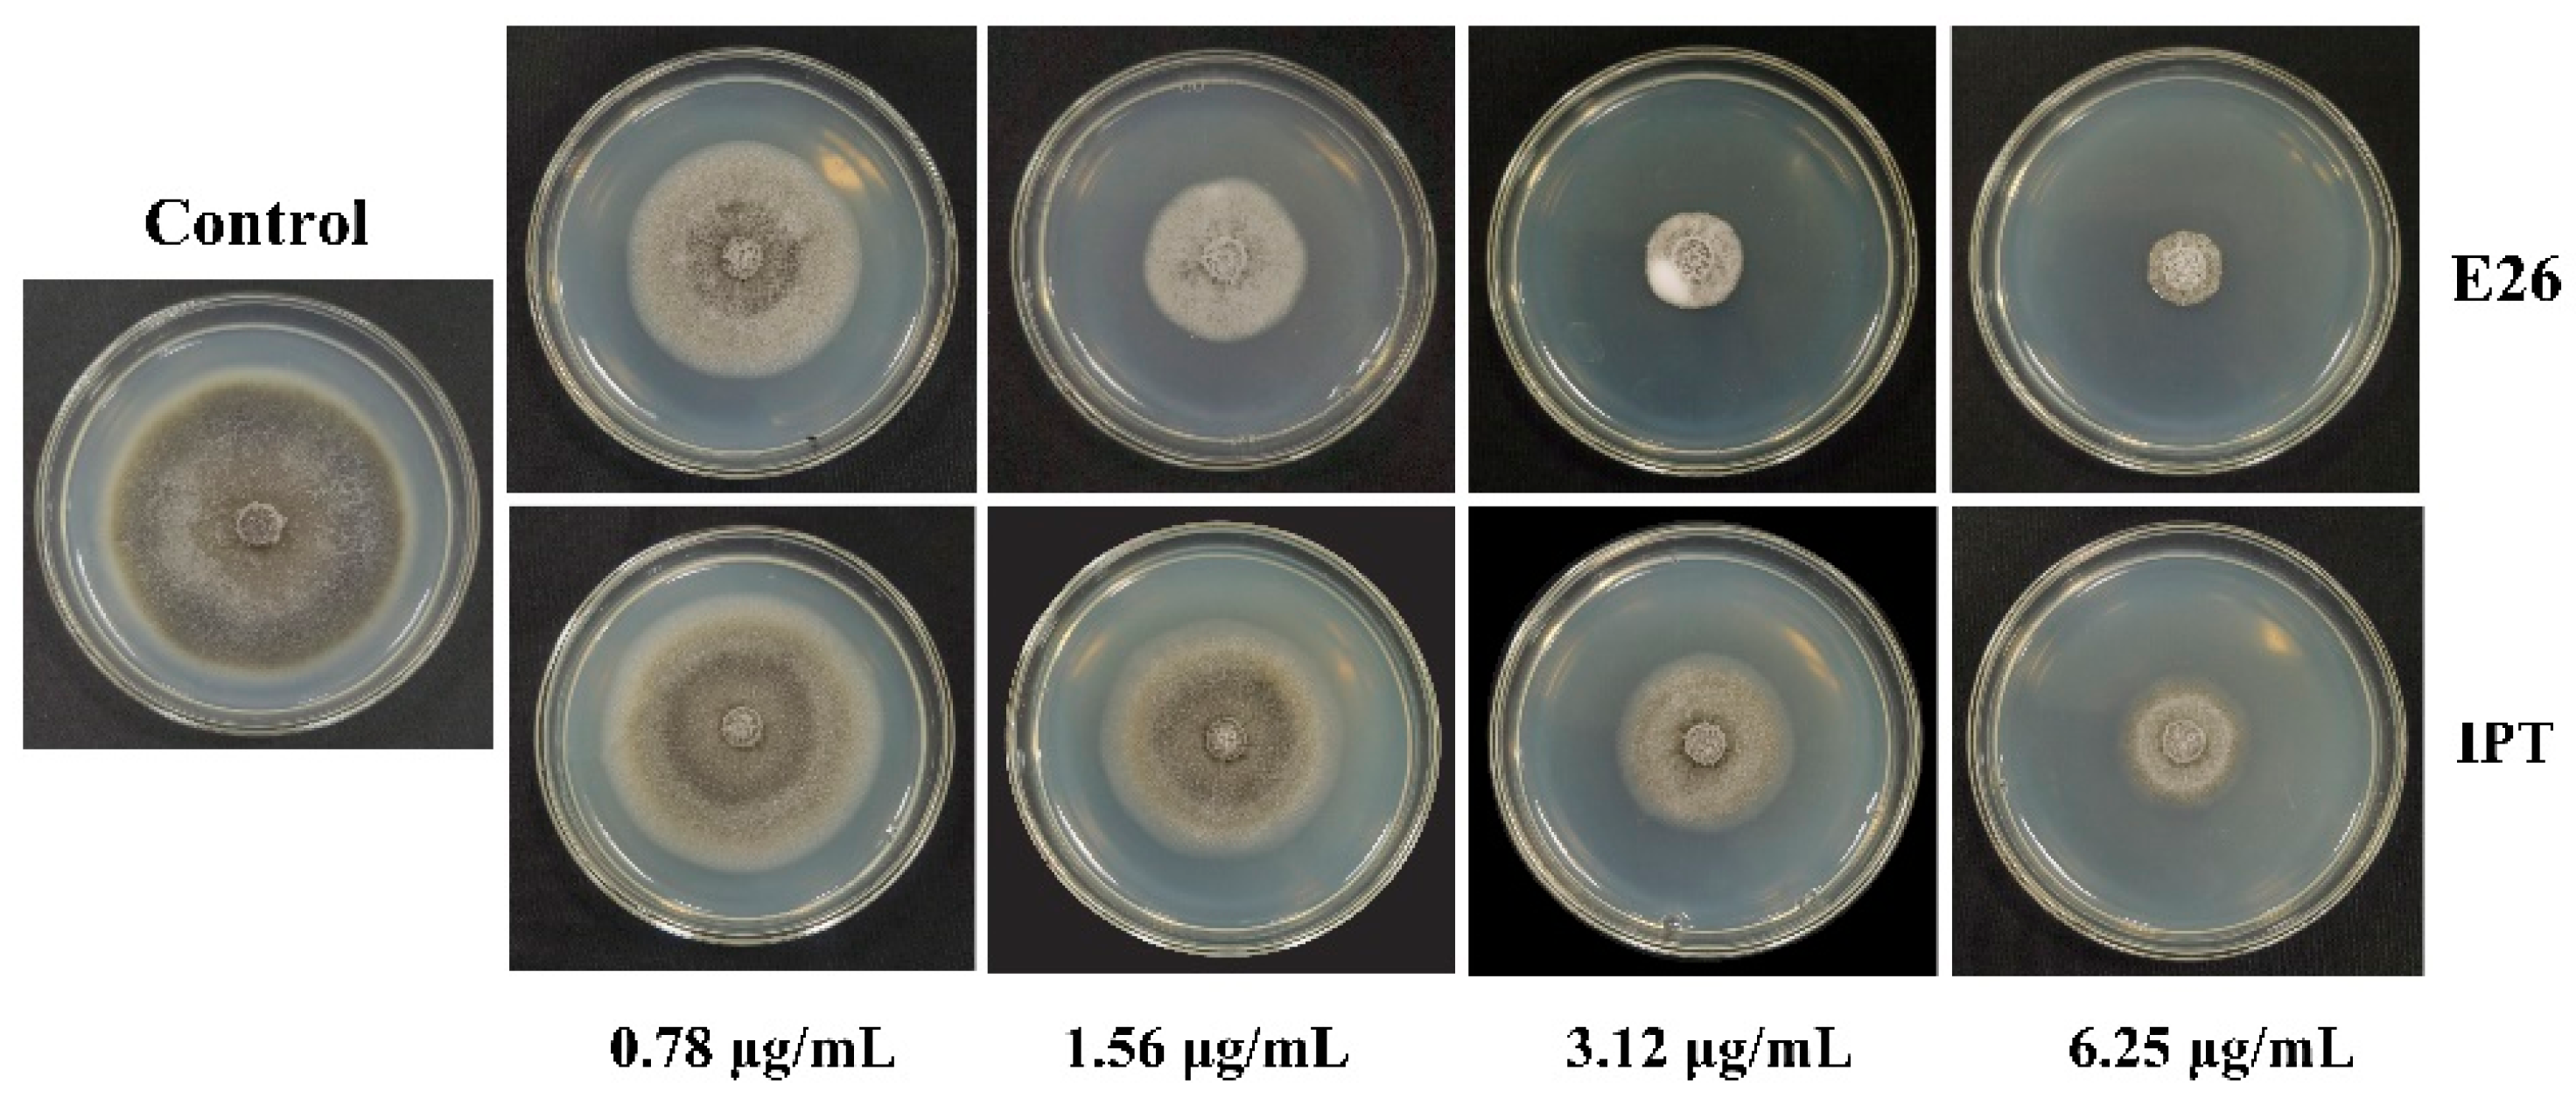

Design, Synthesis, and Antifungal Activity of Some Novel Phenylthiazole Derivatives Containing an Acylhydrazone Moiety
Abstract
:1. Introduction
2. Result and Discussion
2.1. Chemistry
2.2. Antifungal Activity
3. Materials and Methods
3.1. Reagents and Analysis
3.2. Phytopathogenic Fungi
3.3. Synthesis
3.3.1. General Procedure for the Preparation of Intermediates B
3.3.2. General Procedure for the Preparation of Intermediates C
3.3.3. General Procedure for the Preparation of Intermediates D
3.3.4. Preparation Procedure of the Target Compounds E1–E45
3.4. Antifungal Bioassay
4. Conclusions
Supplementary Materials
Author Contributions
Funding
Institutional Review Board Statement
Informed Consent Statement
Data Availability Statement
Conflicts of Interest
Sample Availability
References
- Zhang, C.; Zhao, C.; Zheng, H.; Li, L.; Zheng, Y.; Wu, Z. Design, Synthesis, and Study of the Dual Action Mode of Novel N-Thienyl-1, 5-disubstituted-4-pyrazole Carboxamides against Nigrospora oryzae. J. Agric. Food Chem. 2023, 71, 7210–7220. [Google Scholar] [CrossRef] [PubMed]
- Chen, L.; Zhao, B.; Fan, Z.; Hu, M.; Li, Q.; Hu, W.; Li, J.; Zhang, J. Discovery of novel isothiazole, 1, 2, 3-thiadiazole, and thiazole-based cinnamamides as fungicidal candidates. J. Agric. Food Chem. 2019, 67, 12357–12365. [Google Scholar] [CrossRef] [PubMed]
- Yoon, M.-Y.; Kim, Y.S.; Ryu, S.Y.; Choi, G.J.; Choi, Y.H.; Jang, K.S.; Cha, B.; Han, S.-S.; Kim, J.-C. In vitro and in vivo antifungal activities of decursin and decursinol angelate isolated from Angelica gigas against Magnaporthe oryzae, the causal agent of rice blast. Pestic. Biochem. Phys. 2011, 101, 118–124. [Google Scholar] [CrossRef]
- Xu, S.; Wang, B.; Li, L.; Zhou, Q.; Tian, M.; Zhao, X.; Peng, J.; Liu, F.; Chen, Y.; Xu, Y.; et al. Effects of camptothecin on the rice blast fungus Magnaporthe oryzae. Pestic. Biochem. Phys. 2020, 163, 108–116. [Google Scholar] [CrossRef]
- Asibi, A.E.; Chai, Q.; Coulter, J.A. Rice Blast: A Disease with Implications for Global Food Security. Agronomy 2019, 9, 451. [Google Scholar] [CrossRef]
- Ngo, M.T.; Han, J.W.; Yoon, S.; Bae, S.; Kim, S.-Y.; Kim, H.; Choi, G.J. Discovery of new triterpenoid saponins isolated from Maesa japonica with antifungal activity against rice blast fungus Magnaporthe oryzae. J. Agric. Food Chem. 2019, 67, 7706–7715. [Google Scholar] [CrossRef]
- Wang, R.; Du, S.; Wang, J.; Chu, Q.; Tang, C.; Zhang, Z.; Yang, C.; He, Y.; Li, H.; Wu, T.; et al. Design, synthesis, and antifungal evaluation of Luotonin a derivatives against phytopathogenic fungi. J. Agric. Food Chem. 2021, 69, 14467–14477. [Google Scholar] [CrossRef]
- Phillips, M.W.A. Agrochemical industry development, trends in R&D and the impact of regulation. Pest Manag. Sci. 2020, 76, 3348–3356. [Google Scholar]
- Sparks, T.C.; Lorsbach, B.A. Perspectives on the agrochemical industry and agrochemical discovery. Pest Manag. Sci. 2017, 73, 672–677. [Google Scholar] [CrossRef]
- Gao, Y.; Xu, R.; Gu, S.; Chen, K.; Li, J.; He, X.; Shang, S.; Song, Z.; Song, J. Discovery of natural rosin derivatives containing oxime ester moieties as potential antifungal agents to control tomato gray mold caused by Botrytis cinerea. J. Agric. Food Chem. 2022, 70, 5551–5560. [Google Scholar] [CrossRef]
- Kang, J.; Gao, Y.; Zhang, M.; Ding, X.; Wang, Z.; Ma, D.; Wang, Q. Streptindole and its derivatives as novel antiviral and anti-phytopathogenic fungus agents. J. Agric. Food Chem. 2020, 68, 7839–7849. [Google Scholar] [CrossRef] [PubMed]
- Lorsbach, B.A.; Sparks, T.C.; Cicchillo, R.M.; Garizi, N.V.; Hahn, D.R.; Meyer, K.G. Natural products: A strategic lead generation approach in crop protection discovery. Pest Manag. Sci. 2019, 75, 2301–2309. [Google Scholar] [CrossRef] [PubMed]
- Fu, P.; MacMillan, J.B. Thiasporines A-C, thiazine and thiazole derivatives from a marine-derived Actinomycetospora chlora. J. Nat. Prod. 2015, 78, 548–551. [Google Scholar] [CrossRef] [PubMed]
- Liu, Y.; Ma, Z.; Zhao, X.; Shan, Q.; He, P.; Du, Y.; Wang, Y. Simple and Efficient Synthesis of Anithiactins A-C, Thiasporine A and Their Potent Antitumor 2, 4-Linked Oligothiazole Derivatives. ChemistrySelect 2019, 4, 742–746. [Google Scholar] [CrossRef]
- Shi, J.; Chen, S.; Zhu, X.; Zhang, Y.; Li, J. Synthesis and Bioactivity of Thiasporine A and Its Analogues. Agrochemicals 2021, 60, 878–881. [Google Scholar]
- Zhang, Y.; Shi, J.; Hu, Y.; Liao, C.; Wang, M.; Zhu, X.; Yu, L.; Li, J. Synthesis and fungicidal activity of the N-(phenyl) thiazolamide derivatives. Chin. J. Syn. Chem. 2023. Available online: https://kns.cnki.net/kcms/detail/51.1427.O6.20230427.1424.004.html (accessed on 13 October 2023).
- Chen, S.; Zhu, X.; Shi, J.; Wang, M.; Hu, C.; Liao, C.; Zhang, Y.; Li, J. Design, synthesis and fungicidal activities of Thiasporine A analogues. Chin. J. Pestic. Sci. 2022, 24, 280–288. [Google Scholar]
- Shi, J.; Tian, Y.; Chen, S.; Liao, C.; Mao, G.; Deng, X.; Yu, L.; Zhu, X.; Li, J. Design, synthesis and antifungal evaluation of phenylthiazole-1, 3, 4-oxadiazole thione (ketone) derivatives inspired by natural thiasporine A. Pest Manag. Sci. 2023, 79, 3439–3450. [Google Scholar] [CrossRef]
- Xu, R.; Gu, S.; Chen, K.; Chen, J.; Wang, Y.; Gao, Y.; Shang, S.; Song, Z.; Song, J.; Li, J. Discovery of rosin-based acylhydrazone derivatives as potential antifungal agents against rice Rhizoctonia solani for sustainable crop protection. Pest Manag. Sci. 2023, 79, 655–665. [Google Scholar] [CrossRef]
- Liu, Y.; Song, H.; Huang, Y.; Li, J.; Zhao, S.; Song, Y.; Yang, P.; Xiao, Z.; Liu, Y.; Li, Y.; et al. Design, synthesis, and antiviral, fungicidal, and insecticidal activities of tetrahydro-β-carboline-3-carbohydrazide derivatives. J. Agric. Food Chem. 2014, 62, 9987–9999. [Google Scholar] [CrossRef]
- Malik, M.A.; Al-Thabaiti, S.A.; Malik, M.A. Synthesis, structure optimization and antifungal screening of novel tetrazole ring bearing acyl-hydrazones. Int. J. Mol. Sci. 2012, 13, 10880–10898. [Google Scholar] [CrossRef] [PubMed]
- Zhang, J.; Yang, R.; Li, L.; Liu, J.; Liu, Y.; Song, H.; Wang, Q. Design, synthesis, and bioactivity study of novel tryptophan derivatives containing azepine and acylhydrazone moieties. Molecules 2022, 27, 6700. [Google Scholar] [CrossRef]
- Chen, L.; Xie, J.; Song, H.; Liu, Y.; Gu, Y.; Wang, L.; Wang, Q. Design, synthesis, and biological activities of spirooxindoles containing acylhydrazone fragment derivatives based on the biosynthesis of alkaloids derived from tryptophan. J. Agric. Food Chem. 2016, 64, 6508–6516. [Google Scholar] [CrossRef] [PubMed]
- Zhang, J.; Li, X.; Dong, Y.; Qin, Y.; Li, X.; Song, B.; Yang, X. Synthesis and biological evaluation of 4-methyl-1, 2, 3-thiadiazole-5-carboxaldehyde benzoyl hydrazone derivatives. Chin. Chem. Lett. 2017, 28, 1238–1242. [Google Scholar] [CrossRef]
- Zhang, J.; Wei, C.; Li, S.; Hu, D.; Song, B. Discovery of novel bis-sulfoxide derivatives bearing acylhydrazone and benzothiazole moieties as potential antibacterial agents. Pestic. Biochem. Phys. 2020, 167, 104605. [Google Scholar] [CrossRef]
- Zhou, Z.; Zhou, T. Synthesis and antibacterial activity of C-7 acylhydrazone derivatives of dehydroabietic acid. J. Chem. Res. 2018, 42, 405–407. [Google Scholar] [CrossRef]
- Lu, Y.; Zhao, Z.; Chen, Y.; Wang, J.; Xu, S.; Gu, Y. Synthesis and biological activity of pyridine acylhydrazone derivatives of isopimaric acid. J. Asian Nat. Prod. Res. 2021, 23, 545–555. [Google Scholar] [CrossRef] [PubMed]
- Ren, Z.; Lv, M.; Sun, Z.; Li, T.; Zhang, S.; Xu, H. Regioselective hemisynthesis and insecticidal activity of C8-hydrazones/acylhydrazones/sulfonylhydrazones coumarin-type derivatives of osthole. Bioorg. Med. Chem. Lett. 2021, 40, 127962. [Google Scholar] [CrossRef]
- Wang, Z.; Xie, D.; Gan, X.; Zeng, S.; Zhang, A.; Yin, L.; Song, B.; Jin, L.; Hu, D. Synthesis, antiviral activity, and molecular docking study of trans-ferulic acid derivatives containing acylhydrazone moiety. Bioorg. Med. Chem. Lett. 2017, 27, 4096–4100. [Google Scholar] [CrossRef]
- Ni, W.; Song, H.; Wang, L.; Liu, Y.; Wang, Q. Design, Synthesis and Various Bioactivity of Acylhydrazone-Containing Matrine Analogues. Molecules 2023, 28, 4163. [Google Scholar] [CrossRef]
- Kassab, A.E. Anticancer agents incorporating the N-acylhydrazone scaffold: Progress from 2017 to present. Arch. Pharm. 2023, 356, 2200548. [Google Scholar] [CrossRef]
- Shin, S.Y.; Lee, J.; Ahn, S.; Yoo, M.; Lee, Y.H.; Koh, D.; Lim, Y. Design, synthesis, and evaluation of 4-chromenone derivatives combined with N-acylhydrazone for aurora kinase A inhibitor. Appl. Biol. Chem. 2021, 64, 21. [Google Scholar] [CrossRef]
- Seitz, T.; Fu, P.; Haut, F.-L.; Adam, L.; Habicht, M.; Lentz, D.; MacMillan, J.B.; Christmann, M. One-pot synthesis of 5-hydroxy-4 H-1, 3-thiazin-4-ones: Structure revision, synthesis, and NMR shift dependence of thiasporine A. Org. Lett. 2016, 18, 3070–3073. [Google Scholar] [CrossRef]
- Guo, J.; Hao, Y.; Ji, X.; Wang, Z.; Liu, Y.; Ma, D.; Li, Y.; Pang, H.; Ni, J.; Wang, Q. Optimization, Structure–Activity Relationship, and Mode of Action of Nortopsentin Analogues Containing Thiazole and Oxazole Moieties. J. Agric. Food Chem. 2019, 67, 10018–10031. [Google Scholar] [CrossRef] [PubMed]
- Li, Z.; Chen, Y.; Zhou, Z.; Deng, L.; Xu, Y.; Hu, L.; Liu, B.; Zhang, L. Discovery of first-in-class thiazole-based dual FFA1/PPARδ agonists as potential anti-diabetic agents. Eur. J. Med. Chem. 2019, 164, 352–365. [Google Scholar] [CrossRef] [PubMed]
- Liu, L.; Tan, C.; Fan, R.; Wang, Z.; Du, H.; Xu, K.; Tan, J. I2/TBHP-Mediated tandem cyclization and oxidation reaction: Facile access to 2-substituted thiazoles and benzothiazoles. Org. Biomol. Chem. 2019, 17, 252–256. [Google Scholar] [CrossRef]
- Thore, S.N.; Gupta, S.V.; Baheti, K.G. Docking, synthesis, and pharmacological investigation of novel substituted thiazole derivatives as non-carboxylic, anti-inflammatory, and analgesic agents. Med. Chem. Res. 2013, 22, 3802–3811. [Google Scholar] [CrossRef]

| Compound | Mean Inhibition Rate ± SD (%) (n = 3) | |||
|---|---|---|---|---|
| M. oa | C. c | B. m | S. s | |
| E1 | <10 | 29.19 ± 2.49 | <10 | 15.98 ± 0.82 |
| E2 | <10 | 21.14 ± 0.9 | <10 | 31.66 ± 0.35 |
| E3 | <10 | 19.46 ± 0.65 | <10 | 38.17 ± 0.91 |
| E4 | 88.25 ± 0.17 | 60.74 ± 0.23 | 29.51 ± 0.95 | 22.78 ± 0.4 |
| E5 | 25.2 ± 1.08 | 24.83 ± 2.42 | 12.5 ± 1.7 | 37.57 ± 1.91 |
| E6 | <10 | <10 | <10 | 38.17 ± 0.91 |
| E7 | <10 | 19.46 ± 0.47 | <10 | 15.38 ± 1.78 |
| E8 | <10 | 16.44 ± 2.61 | <10 | 22.49 ± 0.46 |
| E9 | 15.94 ± 1.6 | 16.78 ± 0.54 | <10 | 27.81 ± 1.33 |
| E10 | 85.75 ± 0.8 | 66.44 ± 2.28 | <10 | 34.32 ± 0.62 |
| E11 | 78.63 ± 0.76 | 68.12 ± 1.71 | 19.44 ± 0.64 | 21.89 ± 1.25 |
| E12 | 21.99 ± 2.86 | 10.4 ± 1.56 | <10 | 28.4 ± 1.47 |
| E13 | <10 | 10.74 ± 2.03 | <10 | 12.13 ± 0.45 |
| E14 | 84.00 ± 2.86 | 44.3 ± 1.63 | 22.92 ± 0.24 | 15.38 ± 1.78 |
| E15 | 71.41 ± 2.15 | <10 | 17.36 ± 0.63 | 17.46 ± 1.82 |
| E16 | 64.35 ± 1.41 | 28.52 ± 2.06 | 12.85 ± 0.49 | 19.82 ± 1.28 |
| E17 | 81.40 ± 0.34 | 33.22 ± 2.79 | 13.89 ± 1.45 | 23.08 ± 0.12 |
| E18 | <10 | <10 | 12.85 ± 0.49 | 15.68 ± 1.37 |
| E19 | <10 | 11.07 ± 2.59 | <10 | 35.5 ± 1.45 |
| E20 | 74.16 ± 2.25 | 52.01 ± 0.88 | 15.63 ± 0.16 | <10 |
| E21 | <10 | <10 | 13.89 ± 2.9 | 20.12 ± 2.76 |
| E22 | 56.01 ± 1.49 | 28.19 ± 1.87 | 15.97 ± 2.45 | 21.6 ± 0.47 |
| E23 | 80.12 ± 0.87 | 37.25 ± 0.83 | <10 | <10 |
| E24 | <10 | 18.12 ± 5.12 | 12.85 ± 0.49 | <10 |
| E25 | <10 | 11.07 ± 1.01 | 11.11 ± 1.21 | <10 |
| E26 | 90.74 ± 0.74 | 68.12 ± 1.27 | 30.21 ± 1.77 | 18.64 ± 0.81 |
| E27 | 83.32 ± 0.76 | 45.64 ± 0.31 | 26.04 ± 0.77 | 25.15 ± 2.6 |
| E28 | <10 | 19.46 ± 1.27 | 22.22 ± 2.24 | <10 |
| E29 | <10 | <10 | 13.54 ± 0.14 | <10 |
| E30 | <10 | <10 | <10 | 14.2 ± 1.84 |
| E31 | <10 | 24.5 ± 2.4 | 18.40 ± 3.18 | 15.09 ± 0.82 |
| E32 | 69.03 ± 1.23 | 28.19 ± 1.15 | 24.31 ± 1.93 | <10 |
| E33 | <10 | <10 | 16.32 ± 2 | <10 |
| E34 | <10 | <10 | 20.49 ± 1.22 | 14.2 ± 1.57 |
| E35 | <10 | <10 | 12.5 ± 1.7 | 34.62 ± 0.9 |
| E36 | <10 | <10 | 14.93 ± 1.49 | <10 |
| E37 | <10 | 21.81 ± 2.95 | 17.71 ± 1.23 | 22.49 ± 1.99 |
| E38 | <10 | <10 | 10.76 ± 0.61 | <10 |
| E39 | <10 | <10 | 11.11 ± 1.53 | 45.56 ± 1.16 |
| E40 | <10 | <10 | 14.93 ± 2.07 | 28.7 ± 1.25 |
| E41 | 66.90 ± 1.53 | 31.54 ± 1.09 | 15.28 ± 1.5 | <10 |
| E42 | <10 | <10 | <10 | <10 |
| E43 | <10 | 20.47 ± 2.2 | <10 | <10 |
| E44 | <10 | <10 | <10 | 35.5 ± 1.62 |
| E45 | 15.73 ± 0.56 | <10 | 13.89 ± 3.13 | <10 |
| Thiasporine A | <10 | <10 | 10.76 ± 1.48 | 16.27 ± 1.44 |
| IPTb | 91.81 ± 0.72 | 35.57 ± 1.34 | <10 | 75.15 ± 1.48 |
| PCAc | 44.79 ± 1.38 | 46.98 ± 0.89 | 81.94 ± 1.65 | 97.63 ± 0.57 |
| Compound | Regression Equation | R | EC50 (μg/mL) | 95% Confidence Interval (μg/mL) |
|---|---|---|---|---|
| E4 | y = 4.4560 + 2.4582x | 0.99 | 1.66 | 1.4621~1.8953 |
| E10 | y = 4.8513 + 1.2331x | 0.98 | 2.01 | 1.5059~2.6873 |
| E14 | y = 4.1548 + 2.3913x | 0.99 | 2.26 | 2.0124~2.5302 |
| E17 | y = 4.7745 + 1.3753x | 0.98 | 1.45 | 1.1513~1.8211 |
| E23 | y = 4.8359 + 0.9221x | 0.99 | 1.50 | 1.1483~1.9762 |
| E26 | y = 4.7570 + 2.1660x | 0.99 | 1.29 | 1.1741~1.4018 |
| E27 | y = 4.2101 + 1.8652x | 0.98 | 2.65 | 2.2483~3.1269 |
| IPTa | y = 4.6250 + 1.0746x | 0.99 | 3.22 | 2.8494~3.6391 |
| PCAb | y = 1.6473 + 2.2696x | 0.99 | 27.87 | 26.5822~29.2249 |
Disclaimer/Publisher’s Note: The statements, opinions and data contained in all publications are solely those of the individual author(s) and contributor(s) and not of MDPI and/or the editor(s). MDPI and/or the editor(s) disclaim responsibility for any injury to people or property resulting from any ideas, methods, instructions or products referred to in the content. |
© 2023 by the authors. Licensee MDPI, Basel, Switzerland. This article is an open access article distributed under the terms and conditions of the Creative Commons Attribution (CC BY) license (https://creativecommons.org/licenses/by/4.0/).
Share and Cite
Tian, Y.; Shi, J.; Deng, X.; Yu, T.; Hu, Y.; Hu, R.; Lei, Y.; Yu, L.; Zhu, X.; Li, J. Design, Synthesis, and Antifungal Activity of Some Novel Phenylthiazole Derivatives Containing an Acylhydrazone Moiety. Molecules 2023, 28, 7084. https://doi.org/10.3390/molecules28207084
Tian Y, Shi J, Deng X, Yu T, Hu Y, Hu R, Lei Y, Yu L, Zhu X, Li J. Design, Synthesis, and Antifungal Activity of Some Novel Phenylthiazole Derivatives Containing an Acylhydrazone Moiety. Molecules. 2023; 28(20):7084. https://doi.org/10.3390/molecules28207084
Chicago/Turabian StyleTian, Yao, Jinchao Shi, Xiaoqian Deng, Tingyu Yu, Yong Hu, Richa Hu, Yufeng Lei, Linhua Yu, Xiang Zhu, and Junkai Li. 2023. "Design, Synthesis, and Antifungal Activity of Some Novel Phenylthiazole Derivatives Containing an Acylhydrazone Moiety" Molecules 28, no. 20: 7084. https://doi.org/10.3390/molecules28207084
APA StyleTian, Y., Shi, J., Deng, X., Yu, T., Hu, Y., Hu, R., Lei, Y., Yu, L., Zhu, X., & Li, J. (2023). Design, Synthesis, and Antifungal Activity of Some Novel Phenylthiazole Derivatives Containing an Acylhydrazone Moiety. Molecules, 28(20), 7084. https://doi.org/10.3390/molecules28207084
